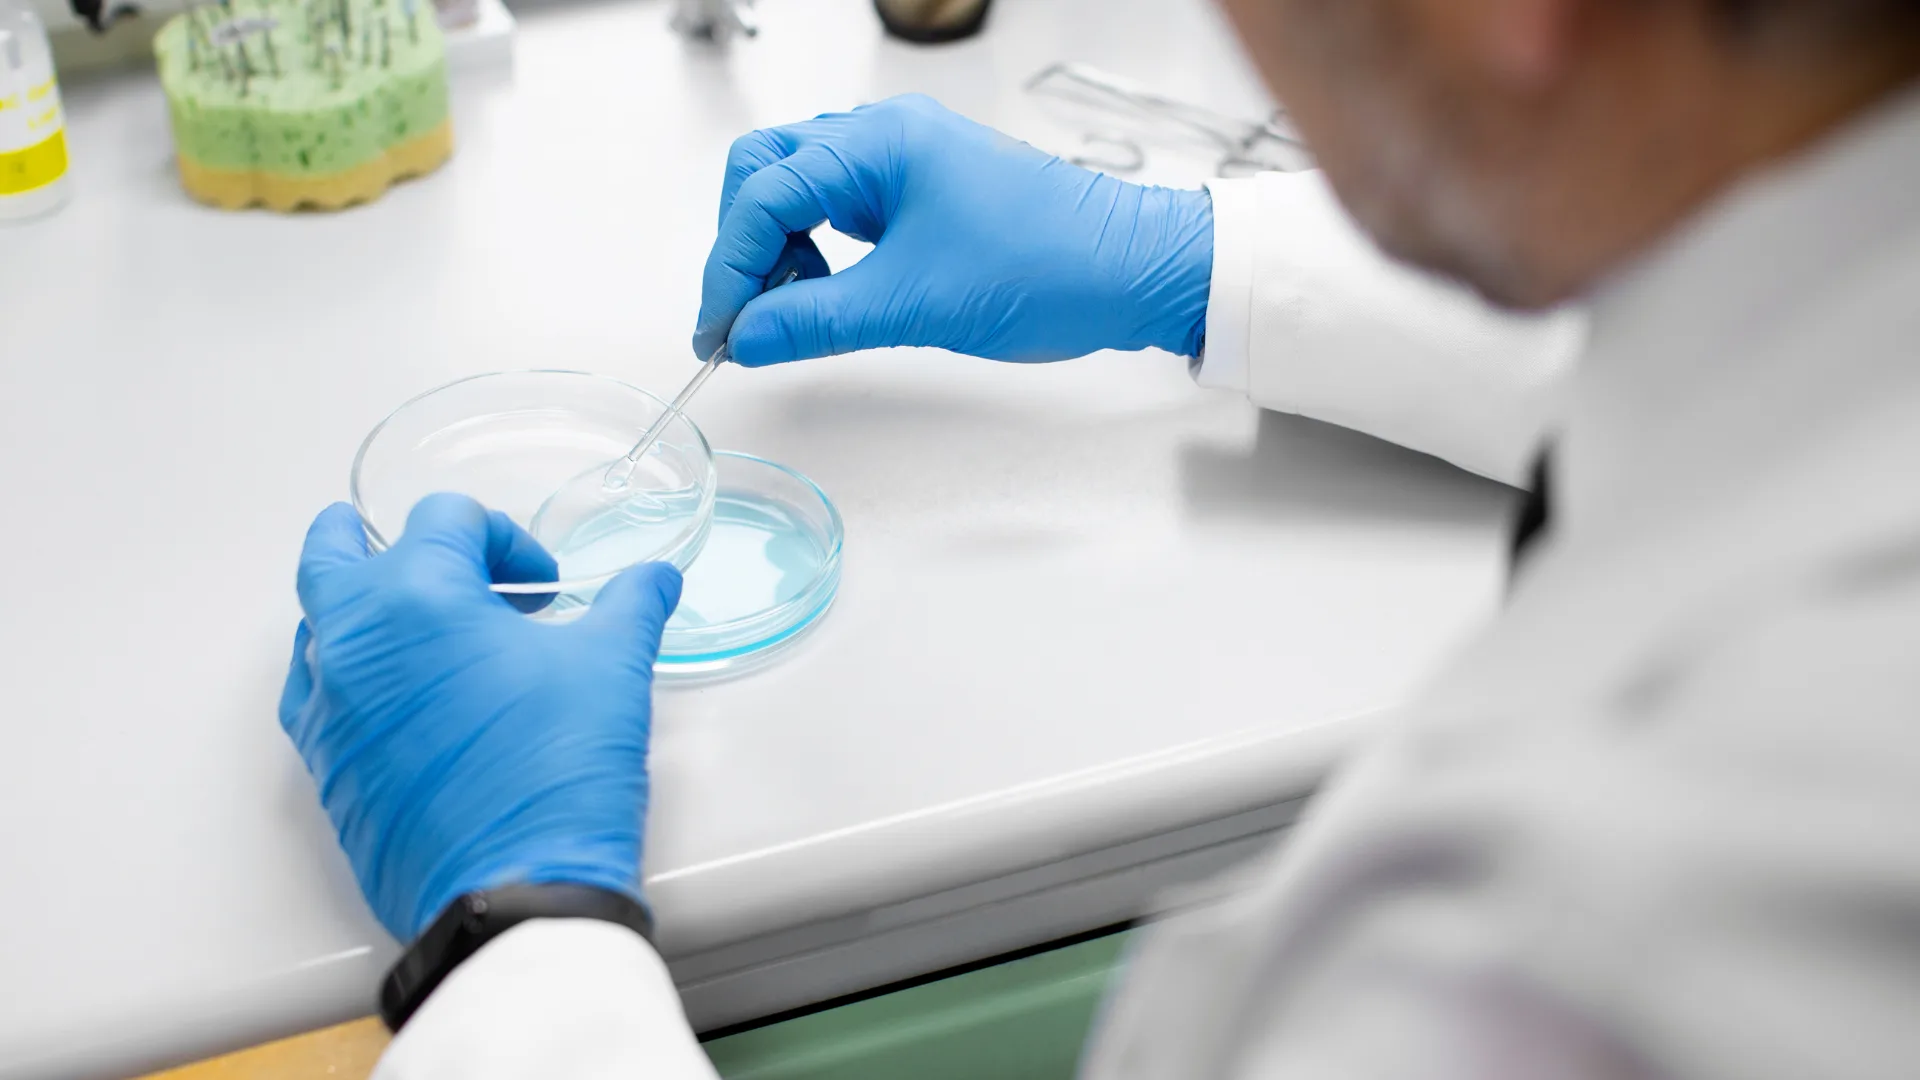

Experience Excellence in Fertility Care
Nurturing possibilities on the journey to parenthood.


About Mediversal Fertility & IVF Clinic
Discovering Possibilities on the Journey of Hope
At Mediversal Fertility & IVF Clinic, we understand the profound desire for parenthood and the unique challenges individuals and couples face on their path to conception. As specialists in fertility treatments, we provide compassionate care, cutting-edge technology, and personalized solutions tailored to your individual needs.
Our approach blends a deep empathy for your parenthood aspirations with a commitment to overcoming fertility obstacles. At Mediversal Fertility & IVF Clinic, we create a supportive and nurturing environment, where every step of your journey is guided by expertise and a profound understanding of your personal journey.
Our Services
Services and Treatments

Fertility Counselling

Ovulation Induction

IUI

IVF

ICSI

Blastocyst Transfer

Egg Freezing

Sperm Freezing

Donor Egg Program

Fertility Preservation

Assisted Hatching

PGT

Fertility Counselling

Ovulation Induction

IUI

IVF

ICSI

Blastocyst Transfer

Egg Freezing

Sperm Freezing

Donor Egg Program

Fertility Preservation

Assisted Hatching
PGT
Unlock fertility possibilities with our expert guidance!
Embark on your parenthood journey with personalized fertility solutions tailored just for you.
Why us?
Our Advantage
Expertise
Comprehensive Services
Patient-Centred Care
Success Rates

Our Experts
Meet Our Experienced Specialists
At Mediversal Fertility and IVF Clinic, we go beyond traditional treatment methods. Our team, comprised of esteemed professionals, leverages innovative techniques and a holistic approach to fertility care. Our facility is equipped with state-of-the-art technology, enabling us to offer a range of advanced reproductive services. We prioritize not just successful outcomes, but also the emotional well-being of our patients, providing a supportive environment throughout your journey to parenthood. Our goal is to make your experience as smooth and stress-free as possible, while maintaining the highest standards of medical excellence.






Sufiya Parween
Dr. Nidhi is very kind and professional. She explains everything clearly and made us feel comfortable. Highly recommend Mediversal IVF for fertility treatment!

Posted on Google
February 10, 2025
Ravikant Kumar
Dr Nidhi Singh is very supportive and listen to all your concerns. The clinic is clean, and the staff is cooperative. Best place for IVF treatment.

Posted on Google
February 7, 2025
Indrajit Kumar
Mediversal IVF is the best IVF center in Patna. Doctor Nidhi Madam treats very well. The child was conceived in the first attempt. Many thanks to all the team members.

Posted on Google
June 05, 2025
Gautam Kumar Verma
We are beyond grateful to Mediversal IVF for making our dream of becoming parents come true! After years of struggling, we finally found hope and expert care here. A special thanks to Dr. Nidhi Singh, whose compassion, expertise, and constant support made all the difference. She explained every step of the IVF process clearly and made us feel confident and cared for throughout our journey. The staff is incredibly kind and professional, and the clinic maintains high standards of hygiene and patient care. Today, we are holding our little bundle of joy, and it’s all thanks to the wonderful team at Mediversal IVF. We highly recommend them to anyone hoping to start their own family.

Posted on Google
June 02, 2025
Get the care you deserve
We offer comprehensive fertility services.
With our team’s expertise and dedication, we provide the highest quality of care for a wide range of fertility and reproductive health needs.
How this works?
- Register by filling out the form
- Book an appointment
- Consultation with a doctor
- We will offer diagnostic services if required
- Pay at the clinic
Schedule a Consultation
"*" indicates required fields

